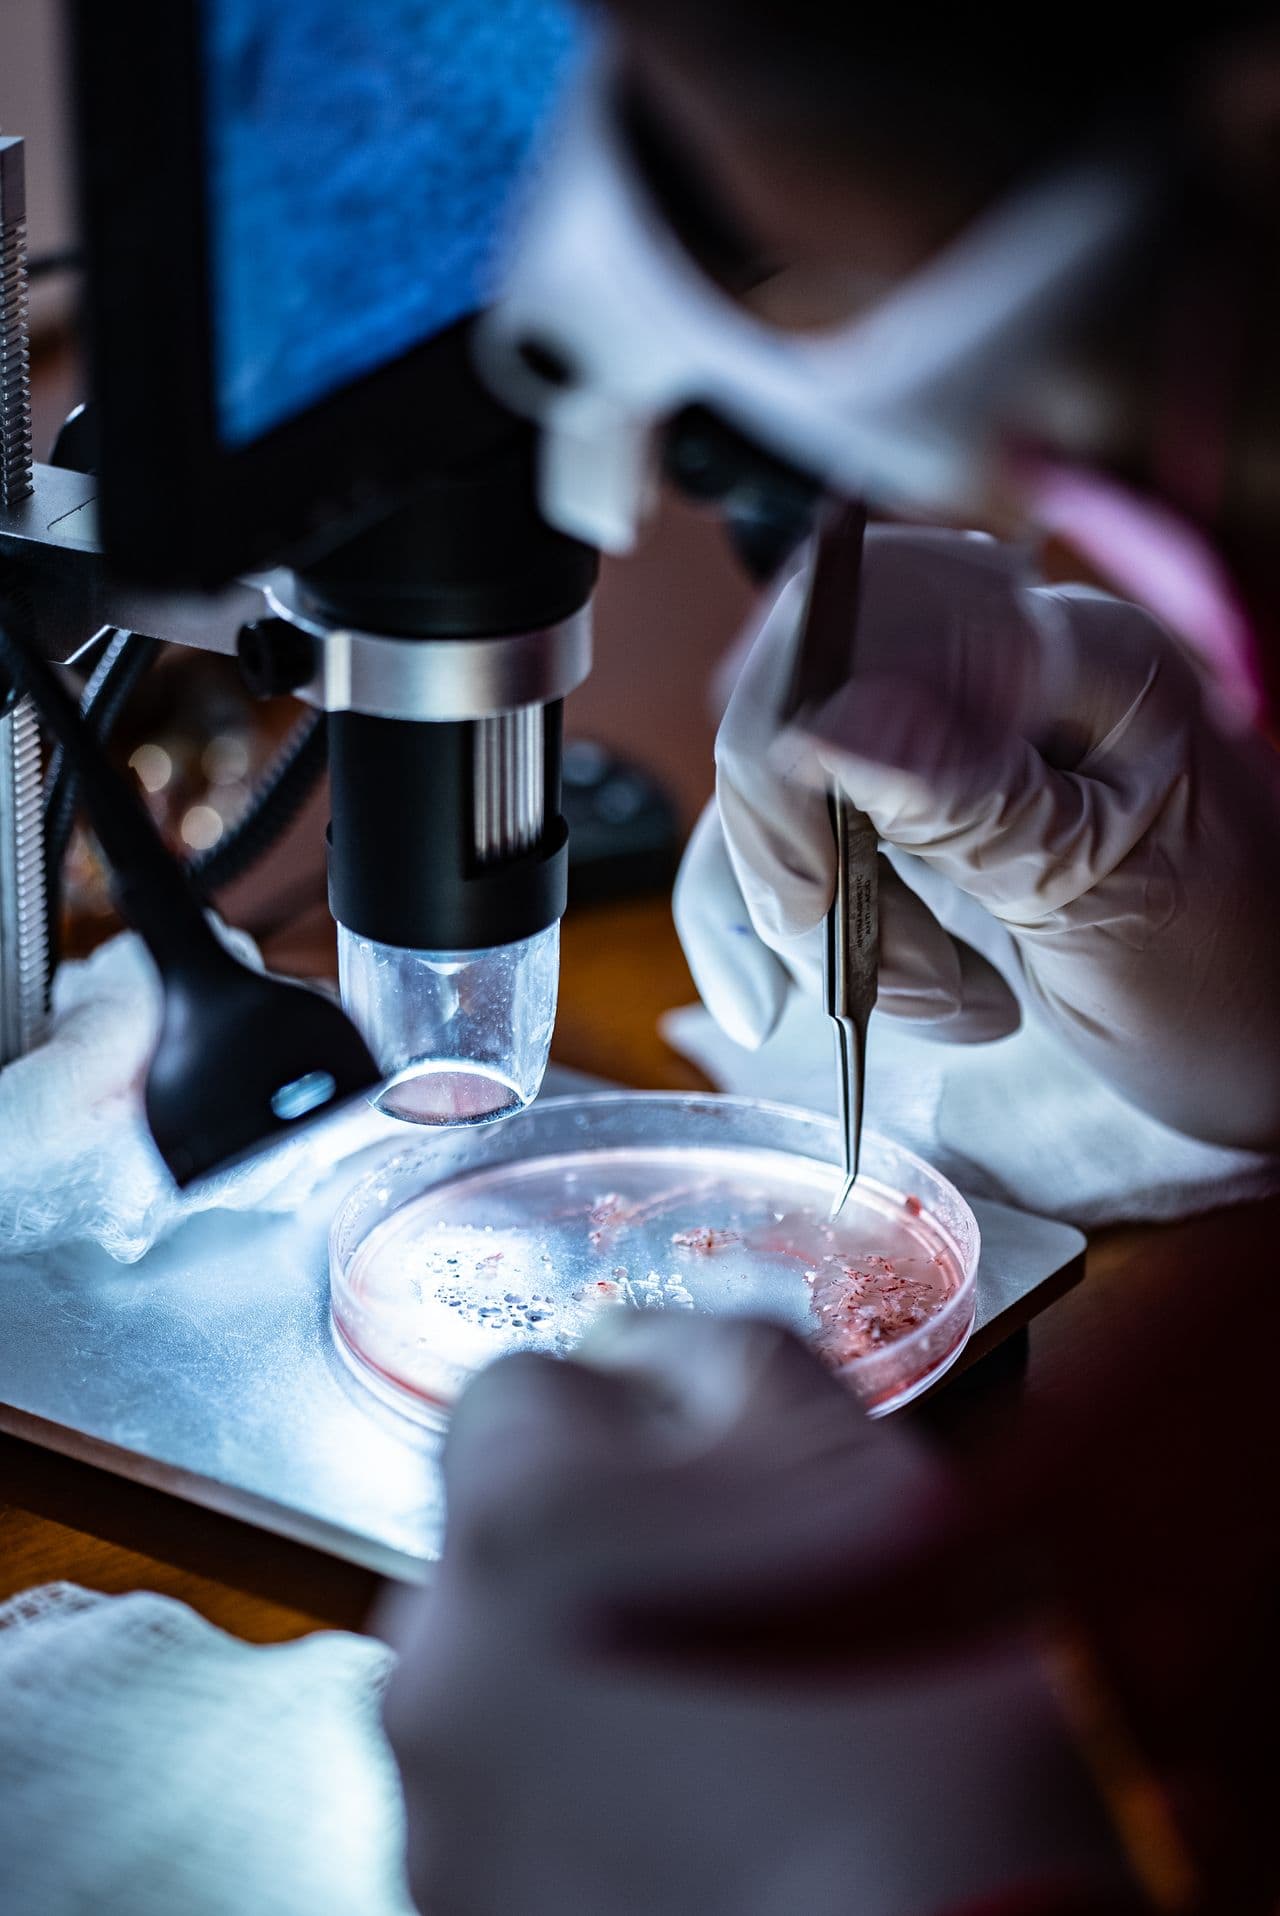
Consultorio Capilar

Especialistas en tricología e injerto capilar con tecnología de punta.
Agenda tu consulta
En Capillarte, combinamos experiencia médica, tecnología capilar y atención empática para ayudarte a verte y sentirte mejor. Tu salud capilar es nuestra prioridad.
Que dicen nuestros pacientesValoración capilar personalizada desde la comodidad de tu casa.
Diagnóstico médico clínico de tu salud capilar en consultorio.
Aplicación de nutrientes en el cuero cabelludo para fortalecer folículos.
Técnica avanzada para restaurar zonas con pérdida de cabello.
Restauración estética de barba, cejas u otras zonas.
Tratamiento médico para frenar la caída capilar hormonal.

Universidad del Valle de Atemajac (2018)
Cédula Profesional: 12963161
Instituto Panamericano de Profesionales Científicos, UNAM (2024)
Universidad en Línea de Madrid (UDIMA), 2024
“Diferencias en el dímero D en pacientes diabéticos y no diabéticos con diagnóstico de TVP”
Instituto Panamericano de Profesionales Científicos (2024)